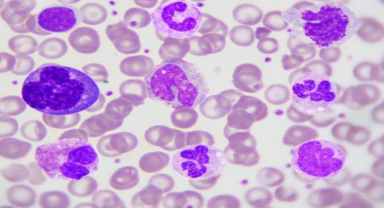
Bazofil Nedir? Bazofillerin Başlıca İşlevleri?

Melih Sakarya Haberleri
Melih Sakarya


05 Kasım 2023 - 10:19
Yara İzi Nedir? Yara İzi Nasıl Geçer?

04 Kasım 2023 - 20:56
İngiliz Karbonatı Nedir? İngiliz Karbonatı Faydaları ve Kullanım Şekilleri Nelerdir?

04 Kasım 2023 - 20:53
Homeopati Nedir? Homeopatinin Faydaları ve Dezavantajları Nelerdir?

04 Kasım 2023 - 20:48
GAPS Diyeti Nedir? Kimlere Uygulanır? Faydaları Nelerdir?

04 Kasım 2023 - 20:23
Açlık Otu Nedir? Açlık Otu Faydaları Nelerdir Nasıl Kullanılır?

04 Kasım 2023 - 20:08
Çinko Nedir? Çinkonun Faydaları Nelerdir?

04 Kasım 2023 - 20:03
Nipah Virüsü Nedir? Nipah Virüsü Enfeksiyonu Nasıl Önlenir?

04 Kasım 2023 - 19:59
Cam Kemik Hastalığı Nedir? Cam Kemik Hastalığının Belirtileri Nelerdir?

04 Kasım 2023 - 19:51
Biberiye Çayı Nedir? Biberiye Çayının Faydaları Nelerdir?

04 Kasım 2023 - 19:47
FibroScan Nedir? FibroScan Hangi Durumlarda Kullanılır?
04 Kasım 2023 - 19:41
Bazofil Nedir? Bazofillerin Başlıca İşlevleri?